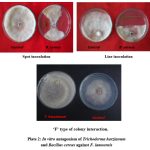

Introduction
One of the most popular and cheapest beverages in the world is tea (Camellia sinensis (L) O. Kuntze) which it is grown in more than 50 countries of the world. The ideal condition for these plant is a warm, humid climate with well distributed rainfall and long sunshine hours. But, along with it the conditions are also favourable for the growth of many pests and pathogens. This results in serious damages affecting productivity and quality. One of the primary root diseases of tea has been identified as brown root rot disease. There is the presence of brown mycellium on root surface to which soil, sand and stone particles remain encrusted 1. Development of the disease is rapid and spreads to other plants through roots. The fungus is pathogenic to as young as one year old to one hundred years old plants 2. The pathogen survives in debris remaining in the soil for more than ten years even after the removal of the diseased plants3. Since the last several decades synthetic chemical fungicides like hexaconaxole, propiconazole, bavistin etc have been used to control the root diseases of tea. But, certain drawbacks like fungicide resistance, effect on the environment etc have been seen. So, there is a necessity of a safer, ecologically tenable practice for disease management. Under the biological control, here is a concept of using plant growth promoting rhizobacteria (PGPR) and plant growth promoting fungi (PGPF) to control the diseases4. As part of an integrated management strategy to control root diseases, there have been efforts to adopt low concentration of chemicals/ non chemicals and bio- agents. The present study is designed to control brown root rot disease of tea by use of bio control agents against the tea root pathogen (F.lamoensis) and their plant growth promotion properties.
Materials and Methods
F. lamoensis isolated was the most dominant root pathogen of tea as it was isolated from most of the tea gardens. F. lamoensis (ITCC 4140) was also procured from the Indian Type Culture Collections (ITCC) of Indian Agricultural Research Institute (IARI), New Delhi for comparison with the new isolate to confirm its identification.
Bacillus cereus and Trichoderma harzianum isolated from the tea rhizosphere were used for the present study.
Isolation of pathogen
Infected roots were collected from various tea gardens of Barak Valley of Assam, N.E. India. They were washed with tap water and cut into small pieces. These pieces were surface sterilized with 1% sodium hypochloride (NaOCl2) for 20 to 40 seconds. Five pieces were placed in each petridishes containing Potato Dextrose Agar (PDA) medium and incubated at 28±2◦C for 7 days. Mycelium grown from inoculated pieces were purified by repeated subculturing and finally transferred to PDA slants and preserved for further study.
Isolation of rhizsophere microbes
Rhizosphere microbes were isolated by serial dilution agar plate technique by using Nutrient Agar (NA) medium. Morphologically dissimilar colonies were purified and stored at 40 Celsius for further studies.
In vitro antagonistic efficacy of B.cereus and T. harzianum
Actively -growing mycelial discs (6 mm) of F. lamoensis were placed in the centre of the Petri plate containing Potato Dextrose Agar medium. A loopful of the B. cereus was spot-inoculated on the periphery of the Petri plate opposite and equidistant from the pathogen placed and incubated at 28±20C. Inhibition zones were measured as distance (in mm) between the respective bacterial test antagonist and the fungal pathogen, F. lamoensis after 7 days of incubation.
Actively growing 4mm disc of T. harzianum were placed in petridishes containing sterile potato dextrose agar medium at 2cm apart from F. lamoensis. The controls sets were made without the T. harzianum. Plates were incubated at 25±10C for 6 days and the growth of the pathogen against the test fungi was measured. The antagonistic ability of the test organism was studied by the method developed by Skidmore and Dickinson 5.
In vitroefficacy of fungicides
The fungicides namely hexaconazole (were used in the present experiment. Three different concentrations i.e.10, 50 and 100 ppm (100 mg/l) of these fungicides were used to test their efficacy against F. lamoensis using the poison food technique 6. Different concentrations of fungicides were prepared by dissolving the required quantity of each fungicide in warm PDA before autoclaving. The autoclaved media was poured into petridishes and were allowed to cool. A total of 45 plates of different fungicides at different concentrations were prepared. Seven day old actively growing culture of F. lamoensis was cut using cork borer into 5 mm diameter discs. The discswere placed at the centre of petridishes. Each treatment was maintained in triplicate. Media without fungicide served as the control. The plates were incubated at 25°C ±2 for 7 days. On the 8th day radial growth of the colony was recorded and the percentage inhibition of growth was calculated using the following formula:
I = 100× (C-T)/C
I= percent inhibition
C= Control
T= Growth of fungus in the treatment.
Efficacy of fungicides and biological control agent in growth promotion and disease suppression under nursery conditions:
One year old tea plants were planted in polythene bags filled up with sterilized garden soil and farm yard manure (FYM) in a ratio of 3:1. Ten days old actively growing culture of F. lamoensis in Potato Dextrose Broth (PDB) was homogenized in sterile distilled water using mortar and pestle. One plant was placed in one bag where these bags were inoculated with homogenized fungal suspension @ 50 ml per plant. Fungicides namely hexaconazole, propiconazole and bavistin were used for treating the plants. At the concentration of 100 ppm the fungicides were applied @ 25 ml per plants. The bags treated only with F. lamoensis served as control. The experiment was laid out in Completely Randomized Design (CRD) with five replications.
B. cereus and T. harzianum were grown separately in Nutrient broth and PDB medium for 48hours respectively. The broth was diluted to 40% and then sprayed over tea plants growing in polythene bags @25 ml per plant near the collar region. Both the treated and control plants were maintained under nursery conditions. Therewere four sets, the first tea plants treated with respective BCA alone, the second set contained tea plants treated with respective BCA + 20 ml of a well homogenized mycelial mixture of the pathogen F. lamoensis. The third setinoculated plants with only 50 ml of well homogenized mycelial mixture of F. lamoensis in sterilized water, whereas the fourth setinoculated tea plants weretreated neither with BCA nor with the pathogen,which served as control. The experiment was laid out in Completely Randomized Design (CRD) with five replications.
Drying and shredding of leaves and drying of entire plants were used for the assessment of disease suppression. Growth improvement of tea was measured in terms of numbers of new leaves, shoot height, root length, dry weight of shoots and dry weight of roots
Statistical analysis
All the data are expressed as mean ± standard error. Data obtained were subjected to statistical analysis as given by Panse and Sukhtame 7 and Gomez and Gomez 8. Significant differences between the treatments were calculated by analysis of variance (ANOVA).
Results and Discussion
In vitro screening of fungicides and BCA against F. lamoensis
The fungicides, hexaconazole, propiconazole and bavistin inhibited the radial growth of the pathogen at different concentrations (i.e. 1, 10, 50 and 100 ppm) with the corresponding days of observation in vitro. Fungicides at 1 and 10 ppm concentrations were less effective and the growth of the pathogen decreased with increase in concentration. Out of the three fungicides tested, no growth of pathogen was recorded in plates treated with 100 ppm hexaconazole during all the days of observation (Fig. 1). In case of plates with 100 ppm propiconazole a slight radial growth of the pathogen was observed (Fig.2). Bavistin treated plates though were initially effective against the pathogen but the effectivity declined with time (Fig. 3 plate 1).
Effect of fungicides on the percent inhibition of the radial growth of F. lamoensis is presented in Figure 4. Hexaconazole completely (100%) inhibited the in vitro radial growth of F. lamoensis, followed by propiconazole 98.51%, Bavistin 12.58%, Roko 5.18% and Ektino 1.48%. It was also observed that hexaconazole at all the concentrations significantly inhibited the growth of thetest pathogen irrespective of the concentrations used (Fig. 4).
In dual culture, the inhibitory ability of B. cereus differed in both spot and line inoculation. The zone of inhibition varied from 10 to 14 mm in Potato Dextrose Agar (PDA). Highest inhibition zone was recorded in line inoculation in PDA medium. On the other hand, T. harzianum also effectively inhibited the pathogen. According to the classification of Skidmore and Dickinson T. harzianum showed ‘F’ type of colony interaction, which meant the pathogen was overgrown by the antagonist (Plate 2).
 |
Figure 1: Effect of different concentrations of hexaconazole on in vitro radial growth of Fomes lamoensis. |
 |
Figure 2: Effect of different concentrations of propiconazole on in vitro radial growth of F. lamoensis. |
 |
Figure 3: Effect of different concentrations of bavistin on in vitro radial growth of F. lamoensis |
 |
Figure 4: Effect of different concentrations of fungicides on percent inhibition of F. lamoensis under in vitro conditions. |
 |
Plate 1: Effect of fungicides (A-Hexaconazole, B-Propiconazole and C-Bavistin) at different concentrations on in vitro growth of F. lamoensis. |
|
Plate 2: In vitro antagonism of Trichoderma harzianum and Bacillus cereus against F. lamoensis |
Growth promotion and disease suppression in tea plants under nursery conditions
Initial symptoms of the disease on tea plants appeared on 30thdays after inoculation and remained prominent up to the 90thday. The leaves started drying followed by shedding of leaves and finally the whole plants died and the roots showed complete rotting. Plants treated with the pathogen along with one of these fungicides i.e. hexaconazole, propiconazole and bavistin initially showed slight leaf drying respectively on 39, 47 and 49thday. On the other hand, the plants treated with pathogen together with B.cereus and T. harzianum showed initial leaf drying followed by shredding on 65th day but, the death of plants, however was not recorded till the 120th days of observation (Table1).
Table 1: Effect of fungicides on the development of brown root rot symptoms in 120 days old tea plants infected by F. lamoensis.
| Treatment (s) | Leaf Drying | Leaf shedding | Drying of tea plants | ||||
| 1 leaf | 2 leaf | More than 2 leaves | 1 leaf | 2 leaf | More than 2 leaves | ||
| Control
(F. lamoensisalone ) |
28thDay | 31stDay | 36th Day | 30th Day | 39th Day | 48th Day | 90th Days |
| Hexaconazole + F. lamoensis | 49th Day | 56th Day | – | 54th Day | 65th Day | – | – |
| Propiconazole + F. lamoensis | 47th Day | 58th Day | – | 52nd Day | – | – | – |
| Bavistin + F. lamoensis | 39th Day | 47th Day | 64th Day | 44th Day | 57th Day | 66th Day | – |
| B. cereus + F. lamoensis | 65th Day | – | – | 77th Day | – | – | – |
| T. harzianum+ F. lamoensis | 65th Day | 78th Day | – | 90th Day | – | – | – |
The treatment with both fungicides and biocontrol agents showed significant growth of tea plants. In the nursery conditions the shoot height, root length, number of leaves and lateral branches showed improvement over the control. Plants treated with hexaconazole and F. lamoensis produced more lateral branches (404.54%) followed by plants treated with 100 ppm propiconazole and F. lamoensis (303%) and bavistin+ F. lamoensis (203.02%) (Fig. 5 and 6). The number of lateral branches, however, did not vary when plants were treated with hexaconazole and propiconazole alone. The plants treated with 100 ppm bavistin produced less number of lateral branches which significantly differed from other treatments including untreated control (203.02%). Hexaconazole treated tea plants produced more new leaves (201.20%) as compared to plants treated with propiconazole (140.96%) and bavistin (60.24%) (Fig.5).
On the other hand, highest per cent increase in shoot height (64.10%) and root length (59.78%) over control was recorded in plants treated with propiconazole + F. lamoensis followed by hexaconazole + F. lamoensis (55.13% and 48.47%). Plants treated with propiconazole (54.57%, 36.16%) and hexaconazole applied alone showed significant shoot height and root length over the control (23.38%, 38.92%) (Fig. 7 and 8) . Least percent increase in both shoot and root height was observed in the plants treated with Bavistin + F. lamoensis (0.06%, 0.02%) and Bavistin alone (0.06%, 0.05%). Pathogen infested control tea plants showed poor shoot height and root length as compared to the fungicide treatments (Plate 3).
The plants treated with biocontrol agents like B. cereus and T. harzianum, with pathogen F. lamoensis have showed increase in the number of new leaves (145.46%) and (8.3%) over the control. The number of lateral branches also increased by 178.57% and 57.51% in both bio control agents. It was also observed that shoot height (98.34%) and root length (127.52%) of plants treated with B. cereus significantly increased over control.
 |
Figure 5: Effect of different treatments on the development of new leaves 120 days after treatment. |
 |
Figure 6: Effect of different treatments on the development of number of lateral branches 120 days after treatment. |
 |
Figure 7: Effect of different treatments on the development of shoot height 120 days after treatment. |
 |
Figure 8: Effect of different treatments on root length120 days after treatment |
 |
Plate 3: Effect of different fungicides (100 ppm) on the shoot height and root length of 120 days old tea plants with or without F. lamoensis under nursery conditions |
Effect of different fungicides and BCA on shoot and root biomass
Both shoot and root dry weight of plants treated with fungicides increased significantly over the untreated control. Highest percent increase in fresh and dry shoot weight (36.95% and 69.04%) was recorded in plants treated with hexaconazole and F. lamoensis. Least increase was recorded in case of plants treated with bavistin (fig 9 & 10).
Highest per-cent increase in fresh and dry root biomass (274.78% and 244.68%) was recorded in case of plants treated with propiconazole and F. lamoensis. Lowest was observed in plants treated with bavistin. It was also found that fungicides hexaconazole, propiconazole and bavistin alone treated tea plants showed significantly increase of biomass over the control (Fig. 11 & 12).
On the other hand, in biocontrol agent treated tea plants both shoot and root biomass also increase significantly over the control. Highest percent in fresh weight of shoot and root was recorded in B. cereus with F. lamoensis treated plants (193.9%, 77.46%) whereas, T. harzianum with pathogen was recorded shoot (19.52%) and root (60.85% ) over the control.
 |
Figure 9: Effect of different treatments on shoot fresh weight 120 days after treatment. |
 |
Figure 10: Effect of different treatments on shootdry weight 120 days after treatment |
 |
Figure 11: Effect of different treatments on root fresh weight 120 days after treatment |
 |
Figure 12: Effect of different treatments on rootdry weight 120 days after treatment |
 |
Figure 13: Effect of different Biocontrol agent (BCA) treatments on growth parameter in tea plants 120 days after treatment |
The antifungal activity of systemic fungicides has been attributed to their ability to inhibit ergosterol bio- synthesis in fungi 9, 10. It has also been reported that hexaconazole and propiconazole are more effective even at low concentrations against fungal pathogen 11. The antifungal acitivity of triflumizole was observed (which act as a selective inhibitor of dimethylation) during the egosterol biosynthesis 12. The increased percent inhibition of the radial growth of the pathogen (F. lamoensis) in hexaconazole and propiconazole treated plants with the increase in concentration. On the other hand, no increase of inhibition was observed in case of bavistin, roko and ektino treatment with the increase in their concentration. Among the systemic fungicides, hexaconazole was found to be highly effective in inhibiting the growth of the pathogen even at the lowest concentration of 10 ppm (86.66%), followed by propiconazole (37.77%). Similar results were also observed with other tea pathogens like Hypoxylon serpens 13, Colletotrichum gloeosporoides 14, Pestalotia theae, Fomes lamoensis 15 and Phomopsis theae 16. Systemic fungicides such as bitertanol has been reported to be effective in controlling grey blight of tea in Korea 17. Evaluation of the number of triazole fungicides in the recent years revealed that the formulation containing cyproconazole, hexaconazole, propiconazole and tebuconazole have been excellent in controlling blister blight of tea 18, 19, 20. The efficacy was improved when triazole were used in combination with copper oxychloride. Strobilurin fungicides were reported to be effective against various pathogen at very low concentrations, (12-20 ppm) 21, 22, 23 found that propiconazole was very effective compared to mancozeb against stripe rust of barley.
In hexaconaxole, propiconazole, and bavistin treated plants shoot height and root length increased with increase in their concentrations used (10,50 and 100 ppm). The fresh and dry weight of shoot and root were also found to be highest in the fungicide treated tea plants as compared to only F. lamoensis inoculated control. The results obtained in the present work are similar to those of Dimond 24, who reported that the chemotherapeutic compounds help to the plants rid get of the established infection. Dutta 25 reported that use of fungicides increased the plant height as well as the yield of tomato. According to Dutta26 the higher yield of the fungicides treated plants is attributed to the change in metabolism of the fungicides treated plants. The increase in yield could also be due to phyto-tonic effect of fungicides. Singh 27 reported that foliar application of propiconazole (tilt 25 EC) @ 0.1% reduced the disease incidence and also gave higher yield over untreated control of barley. Recently, Selvakuma28 reported that application of systemic fungicides (propiconazole, tebuconazole, mancozeb) in barley stripe rust disease not only controlled the disease severity but also increased the yield.
The control of soil borne plant pathogen with the help of antagonists has gained momentum in recent years. From the results of in vitro antagonism study, it was observed that the biological control agents, B.cereusand T. harzianum, inhibited the radial growth of F. lamoensis.In vitro screening of organisms is a valuable tool to select the potential strains of bio-control agents29, 30. This has been reported by several workers 31, 32, 33, 34, 35. Many rhizobacteria including Fluorescent Pseudomonas sp. secrete a variety of antifungal molecules under in vitro and in situ conditions30. Johri36 have also reported the in vitro antagonism of pathogenic fungi and field performance by bacteria isolated from the rhizosphere of crop plants in India.
In the biocontrol disease suppression and growth promotion study in the nursery condition, it was observed that the tea plants treated with the pathogen Fomes lamoensis had shown the highest disease incidence, whereas minimum disease incidence was observed in the antagonistic bacteria and fungi treated tea plants. Besides controlling the diseases, antagonistic fungal and bacterial are also known to enhance plant growth promotion. In the antagonistic biocontrol agents treated tea plants number of new leaves, number of lateral branches, shoot height, root length, fresh weight of shoot and root and dry weight of shoot and root significantly increased in all the treatments. Various plant diseases have been successfully controlled by the application of bacterial and fungal antagonists 37. Most of the early works on biocontrol of plant pathogen by Trichoderma spp. involved direct ability of the fungi to interact with the soil pathogens38.The results obtained in the present work are identical to the works of Barazani 39, 40, 41, 42, 43 who also showed that application of Trichoderma and Sebacimales induced root and shoot growth in Piper dilatatum.
Conclusion
In the present study fungicides hexaconazole and propiconazole at the 100 ppm concentration controlled the brown root rot disease of tea both in in vitro and in nursery conditions. B. cereus and T. harzianum not only showed strong antagonistic activity against the pathogen but also significantly influenced growth of tea plants. Thus it can be proposed as an integrated disease management (IDM) strategy which helps to control tea root pathogen F. lamoensis for the benefits of tea growers at large.
Acknowledgement
First author is thankful to the University Grant Commission (UGC), New Delhi for financial support to carry out this work.
Conflict of Interest
The authors do not have any conflict of interest.
References
- Banerjee B. Tea production and processing. Oxford and IBH Publishing Company Pvt. Ltd. 1993, pp. 243-248.
- Satyanarayana G. Benefit evaluation of soil fumigation in root rot control in tea in NE India. Two and a Bud.1980, 27: 63-64.
- Sarmah K.C. Diseases of tea and associated crops in N.E. India. ITA Memorandum No. 26. 1960, pp 44-46.
- Kloepper J.W. Plant growth promoting rhizobacteria as biological control agents. In: Metting, B. (Ed.) Soil microbiological techniques. Marcel Dekker, New York, NY. 1993: pp255-274.
- Skidmore A.M., Dickinson C.H. Colony interaction and hyphal interference between Septorianodorum and phylloplane fungi. Br. Mycol. Soc. 1976, 66(1):57-64
CrossRef - Dhingra O.D., Sinclair J.B. Basic plant pathology methods. 1985 CRC Press, Inc.: Boca Raton, FL.
- Panse V.G., SukhatmeP.V. Statistical Methods for Agricultural Workers, ICAR Publication, New Delhi.1989, pp 97-156.
- Gomez,K.A., Gomez A.A. Statistical Procedures for Agricultural Research. John Wiley and Sons Publication, New York, 1984.
- Dutta B.K., Debnath S. Disease forecasting as an aid to control blister blight disease of tea caused by Exobasidiumvexans in Darjeeling District. International conference on Tea R&D, 1990: pp: 87-90.
- Zhang Y-Q, Gamarra S., Garcia-Effron G., Park S., Perlin D.S. Requirement for Ergosterol in V-ATPase Function Underlies Antifungal Activity of Azole Drugs. 2010, 6(6): e1000939. doi:10.1371/journal.ppat.1000939
CrossRef - Sarkar S., Narayanan P., Divakaran A., Balamurugan A., Premkumar R. The in vitro effect of certain fungicides, insecticides and biopesticides on mycelial growth in the biocontrol fungus Trichoderma harzianum.Turk. J. Biol.2010, 34: 399-403.
CrossRef - Mizuno M. Triflumizole (Trifmine®). A new broad spectrum fungicides. Japan pesticides information1988, 52. 27-30.
- Onsando J.M. In vitro efficacy of fungicides on Hypoxylon serpens. The casual organism of wood rot of tea. 1986, 7: 4-8.
- Ali MA., Ali M, Huq M, Ahmed M. .In vitro studies on fungicides against Colletorichumgloeosporoides (Penz). Sac.- The die back of tea. S.L.J. Tea Sci. 199362: 25-31.
- Moarng P., Dutta B.K., Dileep Kumar B.S. Efficacy of systemic fungicides against brown root rot disease of tea ( Camellia sinensis (L) O. Kuntze) in vitro and nursery condition. World J. of Agric. Sci. 2012, 8(3):316-321.
- Ponmurugan P., Baby U.I., Gopi C. Efficacy of certain fungicides against Phomopsis theae under in vitro Afri. J. Biotechnol. 2006, 5(5): 434-436.
- Shin G.H., Hur J.S., Koh Y.J.Chemical control of gray blight of tea in Korea. Pathol. J. 2000, 16(3): 162-165.
- Dutta B.K., Debnath S., Pradhan S.K., Gurung R.M. Role of systemic fungicides in the management of blister blight in Darjeeling. Proceedings of 31stTocklai Conference. 1992: pp153-162.
- Premkumar R. Baby U.I., Chandramouli B. Systemic activity and field performance of Triazole fungicides against blister blight pathogen of tea. In: Mathew, N.M., Kuruvilla Jacob eds. Development in plantation crops research. Alled Publishers Limited, New Delhi, 1998, pp: 279-283.
- Nithyameenakshi S., Jeyaramraja P.R., Manian S. Evaluation of azoxystrobin and difenoconazole against certain crop diseases. J. Agric. Res.2010, 5(10): 865-876.
CrossRef - Wong E.P., Wilcox W.E. Sensitivity of azoxystrobin among isolates of Uncinulanecator, Baseline distribution and relationship to myclobutanil sensitivity. Plant Disease. 2002, 86: 394-404.
CrossRef - Miller TC, Gubler WD. Sensitivity of Caliform isolates of Uncinulanecatorto Trifloxystrobin and Spiroxamine, and update on Triadimefon sensitivity. The Amer. Phytopathol. Soc.2004, 88: 1205-1212.
CrossRef - Brahma RN, Asir R. Chemical control of stripe rust of barley with tilt (propiconazole). Indian phytopath. 1988. 41:481-482.
- Dimond AE. In Plant Pathology: Problems and Progress 1908-1958. The golden Jubilee volume of the Phyotopathol. Soc.1967: 221-228.
- Dutta BK. Studies on wilt disease caused by Verticillium albo-atrum & B. in relation to some systemic fungicides. J. Indian bot. Soc, 1980; 59: 81-89.
- Dutta BK. Potential of systemic fungicides in the management of tea diseases. 32ndTocklai conference, TRA, Jorhat, Assam, 1994: pp247-256.
- Singh D.P., Babu K.S., Mann S.K., Madhu Meeta, Karwasra S.S., Kalappanavar I.K., Singh R.N., Singh A.K., Singh S.P. Integrated pest management in barley (Hordeum vulgare). J. Agril. Sc.2010, 80: 437-442.
- Selvakumar R., Madhu Meeta, Shekhawat P.S., Verma R.P.S., Sharma I. Management of stripe rust of barley using fungicides. Indian Phytopathol.2014, 67(2): 138-142.
- Cirvilleri G, Catara V, Bella P, Marchese E. Isolation and characterization of rhizosphere bacteria of potential interest for biological control of soilborne pathogens. Phytophaga. 1999. Suppl. IX: 79-87
- Cook RJ. Making greater use of introduced microorganisms for biological control of plant pathogens. Ann. Rev. Phytopath. 1993. 31: 53-80
CrossRef - Morang P., Devi S., Jha D.K., Dutta B.K., Dileep Kumar B.S. Tea root brown rot fungus disease reduction and yield recovery with rhizobacteria inoculation in both nursery and field trials. 2018, 6:89-97.
CrossRef - Chakraborty BN, Rana S, Das S, Das G, Som R, Datta S, and Chakraborty U. Defense strategies of tea towards foliar pathogens. In: Stress Biology (eds) Chakraborty and B.N. Chakraborty. Narosa Publishing House, New Delhi, India. 2005 pp 208-215.
- Deka Boruah HP, Dileep Kumar BS. Biological activity of the secondary metabolites produced by the Pseudomonas strain RRLJ 008. Folia Microbiol. 2002. 47 (4): 359-363.
CrossRef - Sarmah S.R., Dutta P., Begum R., Tanti A.J., Phukan I., Debnath S., Barthakur B.K. Microbial bioagents for controlling diseases of tea. Proccedings of the International Symposium on Innovation in Tea Science and Sustainable Development in Tea Industry, Hangzhou, China, November 11-15.2005, pp767-776.
- Utkhede R.S., Rahe R.E. Interaction of antagonist and pathogen in biological control of white rot. 1983, 73: 890-893.
CrossRef - Johri B.N. Rao C.V.S., Goel R.Flurescent Pseudomonas in plant disease management. In: Biotechnological Approaches in soil microorganisms for sustainable crop production, Dadarwal, K.R. eds. Scientific Publishers, Jodhpur. 1997.
- Cook JR and Baker KF. The Nature and Practice of Biological Control of Plant Pathogens. APS Press, St. Paul, MN. 1983. pp.539
- Shoresh M., Harman G.E. The relationship between increased growth and resistance induced in plants by root colonizing microbes. Signal. Behav. 2008, 3:737-739
CrossRef - Barazani O, Benderoth M, Groten K, KuhlemeierC, Baldwin IT. Piriformospora indica and Sebacinavermifera increase growth performance at the expense of herbivore resistance in Nicotiana attenuata. Oecologia. (Berlin). 2005. 146:234-243.
CrossRef - Harman GE. Myths and dogmas of biocontrol. Changes in perceptions derived from research on Trichoderma harzianum T-22. Plant Dis.2000, 84:377-393.
CrossRef - Harman G.E., Bjorkman T., Ondik K., Shoresh M. Changing paradigms on the mode of action and uses of Trichoderma spp. for biocontrol. Outlooks pest Manag.2008, 19:24-29.
CrossRef - Peskan-BerghoeferT., Shahollari B., Giong P.H. et al. Association of Piriformospora indica with Arabidopsis thaliana roots represents a novel system to study beneficial plant-microbe interactions and involves early plant protein modifications in the endoplasmic reticulum and at the plasma membrane. Plant. 2004, 122:465-477.
CrossRef - Rai M., Acharya D., Singha A., Verma A. Positive growth responses of the medicinal plants Spilanthes calva and Withbaniasomnifera to inoculation by Piriformospora indica in field trial. Mycorrhiza. 2001, 11:123-128.
CrossRef

